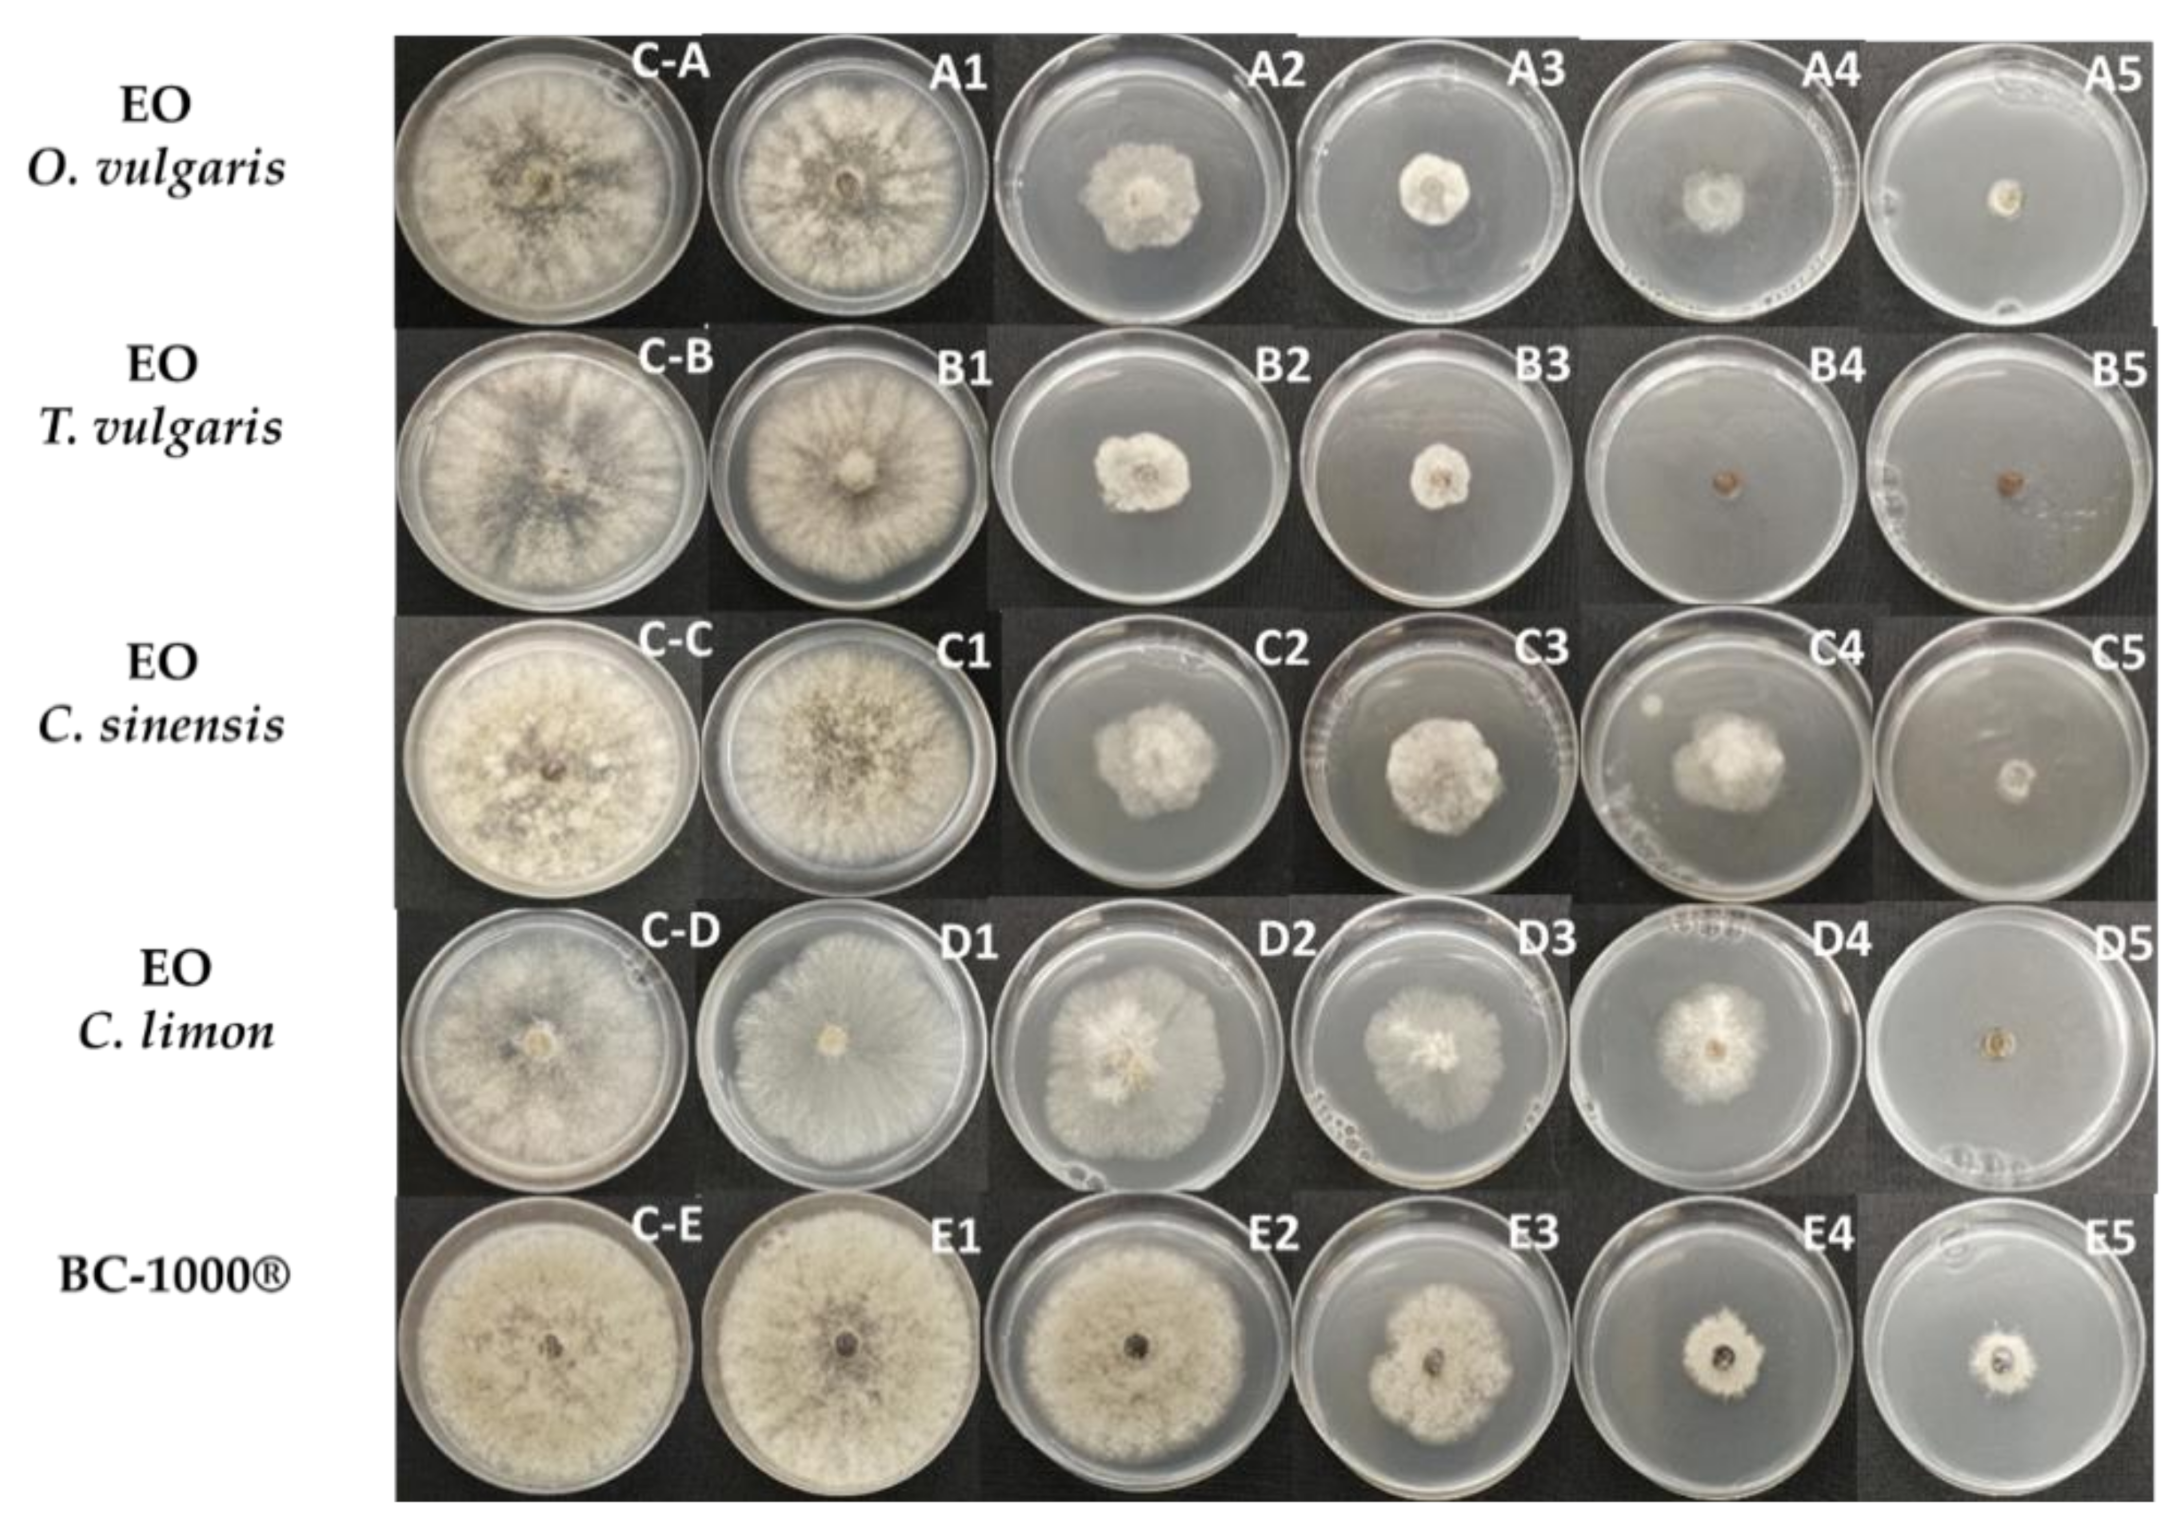
Plants 10 01719 g001

Assessing the Control of Postharvest Gray Mold Disease on Tomato Fruit Using Mixtures of Essential Oils and Their Respective Hydrolates
Abstract
:1. Introduction
2. Results and Discussion
2.1. In Vitro Antifungal Activity of EOs and HYSs
2.2. Chemical Composition of Essential Oils of T. vulgaris and O. vulgare
2.3. In Vivo Assays of Antifungal Activities of EO/HYS Mixtures and HYSs
3. Materials and Methods
3.1. Plant Material
3.2. Extraction of Essential Oils (EOs) and Hydrolates (HYSs)
3.3. Fungal Material
3.4. Preparation of Essential Oil (EO) and Hydrolate (HYS) Solutions
3.5. In Vitro Mycelial Growth Inhibition of Essential Oils and Hydrosols
Agar Dilution Method
3.6. In Vivo Antifungal Activity of HYSs and Mixtures of EO/HYS In Vivo against Gray Mold on Tomato Fruits
3.7. Chromatographic Analyses of O. vulgare and T. vulgaris
4. Conclusions
Supplementary Materials
Author Contributions
Funding
Institutional Review Board Statement
Informed Consent Statement
Data Availability Statement
Acknowledgments
Conflicts of Interest
References
- Jarvis, W. Botryotinia and Botrytis Species: Taxonomy, Physiology and Pathogenicity—A Guide to the Literature; Research Branch, Canada Department of Agriculture: Ottawa, ON, Canada, 1977. [Google Scholar]
- Elad, Y.; Pertot, I.; Prado, A.M.C.; Stewart, A. Plant Hosts of Botrytis spp. In Botrytis—The Fungus, the Pathogen and Its Management in Agricultural Systems; Fillinger, S., Elad, Y., Eds.; Springer International Publishing: Cham, Switzerland, 2016; p. 413. [Google Scholar]
- Fillinger, S.; Walker, A.S. Chemical Control and Resistance Management of Botrytis Diseases. In Botrytis—The Fungus, the Pathogen and Its Management in Agricultural Systems; Fillinger, S., Elad, Y., Eds.; Springer International Publishing: Cham, Switzerland, 2016; p. 189. [Google Scholar]
- Leroux, P. Chemical control of Botrytis and its resistance to chemical fungicides. In Botrytis: Biology, Pathology and Control; Elad, Y., Williamson, B., Tudzynski, P., Delen, N., Eds.; Kluwer Academic Press: Dordrecht, The Netherlands, 2004; pp. 195–222. [Google Scholar]
- Cragg, G.M.; Newman, D.J. Natural products: A continuing source of novel drug leads. Biochim. Biophys. Acta Gen. Subj. 2013, 1830, 3670–3695. [Google Scholar] [CrossRef] [PubMed] [Green Version]
- Cragg, G.M.; Grothaus, P.G.; Newman, D.J. Impact of Natural Products on Developing New Anti-Cancer Agents. Chem. Rev. 2009, 109, 3012–3043. [Google Scholar] [CrossRef]
- Grayer, R.J.; Kokubun, T. Plant-fungal interactions: The search for phytoalexins and other antifungal compounds from higher plants. Phytochemistry 2001, 56, 253–263. [Google Scholar] [CrossRef]
- De Rosa, S.; De Giulio, A.; Iodice, C. Biological Effects of Prenylated Hydroquinones-Structure-Activity Relationship Studies in Antimicrobial, Brine Shrimp, and Fish Lethality Assays. J. Nat. Prod. 1994, 57, 1711–1716. [Google Scholar] [CrossRef]
- Bosio, C.; Tomasoni, G.; Martinez, R.; Olea, A.F.; Carrasco, H.; Villena, J. Cytotoxic and apoptotic effects of leptocarpin, a plant-derived sesquiterpene lactone, on human cancer cell lines. Chem. Biol. Interact. 2015, 242, 415–421. [Google Scholar] [CrossRef]
- Vengurlekar, S.; Sharma, R.; Trivedi, P. Efficacy of some natural compounds as antifungal agents. Pharm. Rev. 2012, 6, 91–99. [Google Scholar] [CrossRef] [Green Version]
- Espinoza, L.; Baeza, E.; Catalan, K.; Osorio, M.; Carrasco, H.; Cuellar, M.; Villena, J. Synthesis and Antitumor Activity of Diterpenylhydroquinone Derivatives of Natural Ent-Labdanes. Molecules 2010, 15, 6502–6511. [Google Scholar] [CrossRef]
- Baeza, E.; Catalan, K.; Villena, J.; Carrasco, H.; Cuellar, M.; Espinoza, L. Synthesis and cytotoxic activity of geranylmethoxyhydroquinone derivatives. J. Chil. Chem. Soc. 2012, 57, 1219–1223. [Google Scholar] [CrossRef] [Green Version]
- Carrasco, H.; Raimondi, M.; Svetaz, L.; Di Liberto, M.; Rodriguez, M.V.; Espinoza, L.; Madrid, A.; Zacchino, S. Antifungal activity of eugenol analogues. Influence of different substituents and studies on mechanism of action. Molecules 2012, 17, 1002–1024. [Google Scholar] [CrossRef] [PubMed] [Green Version]
- Espinoza, L.; Taborga, L.; Diaz, K.; Olea, A.F.; Peña-Cortes, H. Synthesis of linear geranylphenols and their effect on mycelial growth of plant pathogen Botrytis cinerea. Molecules 2014, 19, 1512–1526. [Google Scholar] [CrossRef] [Green Version]
- Taborga, L.; Diaz, K.; Olea, A.F.; Reyes-Bravo, P.; Flores, M.E.; Pena-Cortes, H.; Espinoza, L. Effect of Polymer Micelles on Antifungal Activity of Geranylorcinol Compounds against Botrytis cinerea. J. Agric. Food Chem. 2015, 63, 6890–6896. [Google Scholar] [CrossRef] [PubMed]
- Olea, A.F.; Bravo, A.; Martínez, R.; Thomas, M.; Sedan, C.; Espinoza, L.; Zambrano, E.; Carvajal, D.; Silva-Moreno, E.; Carrasco, H. Antifungal Activity of Eugenol Derivatives against Botrytis cinerea. Molecules 2019, 24, 1239. [Google Scholar] [CrossRef] [Green Version]
- Bakkali, F.; Averbeck, S.; Averbeck, D.; Idaomar, M. Biological effects of essential oils—A review. Food Chem. Toxicol. 2008, 46, 446–475. [Google Scholar] [CrossRef]
- Pandey, A.; Kumar, P.; Singh, P.; Tripathi, N.N.; Bajpai, V. Essential Oils: Sources of Antimicrobials and Food Preservatives. Front. Microbiol. 2017, 7, 2161. [Google Scholar] [CrossRef] [PubMed] [Green Version]
- Stratakos, A.C.; Koidis, A. Chapter 4—Methods for Extracting Essential Oils. In Essential Oils in Food Preservation, Flavor and Safety; Preedy, V.R., Ed.; Academic Press: San Diego, CA, USA, 2016; pp. 31–38. [Google Scholar]
- Lei, G.; Li, J.; Zheng, T.; Yao, J.; Chen, J.; Duan, L. Comparative Chemical Profiles of Essential Oils and Hydrolate Extracts from Fresh Flowers of Eight Paeonia suffruticosa Andr. Cultivars from Central China. Molecules 2018, 23, 3268. [Google Scholar] [CrossRef] [PubMed] [Green Version]
- Değirmenci, H.; Erkurt, H. Relationship between volatile components, antimicrobial and antioxidant properties of the essential oil, hydrosol and extracts of Citrus aurantium L. flowers. J. Infect. Public Health 2020, 13, 58–67. [Google Scholar] [CrossRef] [PubMed]
- Hamdi, A.; Majouli, K.; Vander Heyden, Y.; Flamini, G.; Marzouk, Z. Phytotoxic activities of essential oils and hydrosols of Haplophyllum tuberculatum. Ind. Crop. Prod. 2017, 97, 440–447. [Google Scholar] [CrossRef]
- Soylu, E.M.; Kurt, S.; Soylu, S. In vitro and in vivo antifungal activities of the essential oils of various plants against tomato grey mould disease agent Botrytis cinerea. Int. J. Food Microbiol. 2010, 143, 183–189. [Google Scholar] [CrossRef]
- Tripathi, P.; Dubey, N.K.; Shukla, A.K. Use of some essential oils as post-harvest botanical fungicides in the management of grey mould of grapes caused by Botrytis cinerea. World J. Microbiol. Biotechnol. 2008, 24, 39–46. [Google Scholar] [CrossRef]
- Zhang, J.; Ma, S.; Du, S.; Chen, S.; Sun, H. Antifungal activity of thymol and carvacrol against postharvest pathogens Botrytis cinerea. J. Food Sci. Technol. 2019, 56, 2611–2620. [Google Scholar] [CrossRef]
- Nazzaro, F.; Fratianni, F.; Coppola, R.; Feo, V. Essential Oils and Antifungal Activity. Pharmaceuticals 2017, 10, 86. [Google Scholar] [CrossRef] [Green Version]
- Stević, T.; Berić, T.; Šavikin, K.; Soković, M.; Gođevac, D.; Dimkić, I.; Stanković, S. Antifungal activity of selected essential oils against fungi isolated from medicinal plant. Ind. Crop. Prod. 2014, 55, 116–122. [Google Scholar] [CrossRef]
- D’Amato, S.; Serio, A.; López, C.C.; Paparella, A. Hydrosols: Biological activity and potential as antimicrobials for food applications. Food Control 2018, 86, 126–137. [Google Scholar] [CrossRef]
- Di Vito, M.; Smolka, A.; Proto, M.R.; Barbanti, L.; Gelmini, F.; Napoli, E.; Bellardi, M.G.; Mattarelli, P.; Beretta, G.; Sanguinetti, M.; et al. Is the Antimicrobial Activity of Hydrolates Lower than That of Essential Oils? Antibiotics 2021, 10, 88. [Google Scholar] [CrossRef]
- Tabet Zatla, A.; Dib, M.E.A.; Djabou, N.; Ilias, F.; Costa, J.; Muselli, A. Antifungal activities of essential oils and hydrosol extracts of Daucus carota subsp. sativus for the control of fungal pathogens, in particular gray rot of strawberry during storage. J. Essent. Oil Res. 2017, 29, 391–399. [Google Scholar] [CrossRef]
- Harris, R. Synergism in the essential oil world. Int. J. Aromather. 2002, 12, 179–186. [Google Scholar] [CrossRef]
- Gutierrez, J.; Barry-Ryan, C.; Bourke, P. Antimicrobial activity of plant essential oils using food model media: Efficacy, synergistic potential and interactions with food components. Food Microbiol. 2009, 26, 142–150. [Google Scholar] [CrossRef] [PubMed]
- Rosato, A.; Vitali, C.; Piarulli, M.; Mazzotta, M.; Argentieri, M.P.; Mallamaci, R. In vitro synergic efficacy of the combination of Nystatin with the essential oils of Origanum vulgare and Pelargonium graveolens against some Candida species. Phytomedicine 2009, 16, 972–975. [Google Scholar] [CrossRef] [PubMed]
- Bassolé, I.H.; Juliani, H.R. Essential oils in combination and their antimicrobial properties. Molecules 2012, 17, 3989–4006. [Google Scholar] [CrossRef] [Green Version]
- Ilić, B.S.; Kocić, B.D.; Ćirić, V.M.; Cvetković, O.G.; Miladinović, D.L. An In Vitro Synergistic Interaction of Combinations of Thymus glabrescens Essential Oil and Its Main Constituents with Chloramphenicol. Sci. World J. 2014, 2014, 826219. [Google Scholar] [CrossRef] [Green Version]
- Fu, Y.; Zu, Y.; Chen, L.; Shi, X.; Wang, Z.; Sun, S.; Efferth, T. Antimicrobial activity of clove and rosemary essential oils alone and in combination. Phytother. Res. 2007, 21, 989–994. [Google Scholar] [CrossRef] [PubMed]
- Nikkhah, M.; Hashemi, M.; Najafi, M.B.H.; Farhoosh, R. Synergistic effects of some essential oils against fungal spoilage on pear fruit. Int. J. Food Microbiol. 2017, 257, 285–294. [Google Scholar] [CrossRef]
- Elad, Y.; Gullino, M.L.; Shtienberg, D.; Aloi, C. Managing Botrytis cinerea on tomatoes in greenhouses in the Mediterranean. Crop Prot. 1995, 14, 105–109. [Google Scholar] [CrossRef]
- Wang, J.; Xia, X.-M.; Wang, H.-Y.; Li, P.-P.; Wang, K.-Y. Inhibitory effect of lactoferrin against gray mould on tomato plants caused by Botrytis cinerea and possible mechanisms of action. Int. J. Food Microbiol. 2013, 161, 151–157. [Google Scholar] [CrossRef]
- Romanazzi, G.; Droby, S. Control Strategies for Postharvest Grey Mould on Fruit Crops. In Botrytis—The Fungus, the Pathogen and Its Management in Agricultural Systems; Fillinger, S., Elad, Y., Eds.; Springer International Publishing: Cham, Switzerland, 2016; pp. 217–228. [Google Scholar]
- Zhang, C.-Y.; Guo, M. Comparing Three Different Extraction Techniques on Essential Oil Profiles of Cultivated and Wild Lotus (Nelumbo nucifera) Flower. Life 2020, 10, 209. [Google Scholar] [CrossRef]
- Bhaskara Reddy, M.V.; Angers, P.; Gosselin, A.; Arul, J. Characterization and use of essential oil from Thymus vulgaris against Botrytis cinerea and Rhizopus stolonifer in strawberry fruits. Phytochemistry 1998, 47, 1515–1520. [Google Scholar] [CrossRef]
- Bouchra, C.; Achouri, M.; Hassani, L.M.I.; Hmamouchi, M. Chemical composition and antifungal activity of essential oils of seven Moroccan Labiatae against Botrytis cinerea Pers: Fr. J. Ethnopharmacol. 2003, 89, 165–169. [Google Scholar] [CrossRef]
- Arras, G.; Usai, M. Fungitoxic activity of 12 essential oils against four postharvest citrus pathogens: Chemical analysis of thymus capitatus oil and its effect in subatmospheric pressure conditions. J. Food Prot. 2001, 64, 1025–1029. [Google Scholar] [CrossRef]
- Nieto, G. A Review on Applications and Uses of Thymus in the Food Industry. Plants 2020, 9, 961. [Google Scholar] [CrossRef]
- Marino, A.; Nostro, A.; Mandras, N.; Roana, J.; Ginestra, G.; Miceli, N.; Taviano, M.F.; Gelmini, F.; Beretta, G.; Tullio, V. Evaluation of antimicrobial activity of the hydrolate of Coridothymus capitatus (L.) Reichenb. fil. (Lamiaceae) alone and in combination with antimicrobial agents. BMC Complement Med. Ther. 2020, 20, 89. [Google Scholar] [CrossRef]
- Lee, S.O.; Choi, G.J.; Jang, K.S.; Lim, H.K.; Cho, K.Y.; Kim, J.C. Antifungal activity of five plant essential oils as fumigant against postharvest and soilborne plant pathogenic fungi. Plant Pathol. J. 2007, 23, 97–102. [Google Scholar] [CrossRef]
- Begnini, K.R.; Nedel, F.; Lund, R.G.; Carvalho, P.H.; Rodrigues, M.R.; Beira, F.T.; Del-Pino, F.A. Composition and antiproliferative effect of essential oil of Origanum vulgare against tumor cell lines. J. Med. Food 2014, 17, 1129–1133. [Google Scholar] [CrossRef]
- Balusamy, S.R.; Perumalsamy, H.; Huq, M.A.; Balasubramanian, B. Anti-proliferative activity of Origanum vulgare inhibited lipogenesis and induced mitochondrial mediated apoptosis in human stomach cancer cell lines. Biomed. Pharmacother. 2018, 108, 1835–1844. [Google Scholar] [CrossRef]
- Slaghenaufi, D.; Ugliano, M. Norisoprenoids, Sesquiterpenes and Terpenoids Content of Valpolicella Wines during Aging: Investigating Aroma Potential in Relationship to Evolution of Tobacco and Balsamic Aroma in Aged Wine. Front. Chem. 2018, 6, 66. [Google Scholar] [CrossRef] [Green Version]
- Šernaitė, L.; Rasiukevičiūtė, N.; Valiuškaitė, A. Application of Plant Extracts to Control Postharvest Gray Mold and Susceptibility of Apple Fruits to B. cinerea from Different Plant Hosts. Foods 2020, 9, 1430. [Google Scholar] [CrossRef]
- Townsend, G.R.; Heuberger, J.W. Methods for estimating losses caused by diseases in fungicides experiments. Plant Dis. Report. 1943, 27, 340–343. [Google Scholar]
- Ojeda-Contreras, A.-J.; Hernández-Martínez, J.; Domínguez, Z.; Mercado-Ruiz, J.-N.; Troncoso-Rojas, R.; Sánchez-Estrada, A.; Tiznado-Hernández, M.-E. Utilization of Caffeic Acid Phenethyl Ester to Control Alternaria alternata Rot in Tomato (Lycopersicon esculentum Mill.) Fruit. J. Phytopathol. 2008, 156, 164–173. [Google Scholar] [CrossRef]

| Concentration | * Percentage of Inhibition of Mycelial Growth of B. cinerea (%) ± SD | ||||
|---|---|---|---|---|---|
| %v/v × 10−2 | O. vulgare | T. vulgaris | C. sinensis | C. limon | BC-1000® |
| 0.009 | 9 ± 5.0 a,e | 17 ± 4.1 c | 2 ± 2.0 b,d,e | 12 ± 6.0 a,c | 0 ± 0.0 d |
| 0.045 | 30 ± 4.3 b,d | 24 ± 13.4 c,d | 14 ± 10.2 a,b,c | 12 ± 3.0 a,b,c | 0 ± 0.0 a |
| 0.09 | 38 ± 10.3 e | 36 ± 9.4 e | 19 ± 2.3 b,c | 14 ± 4.5 a,b | 0 ± 0.0 d |
| 0.90 | 59 ± 2.5 b,c,d | 75 ± 7.8 e | 56 ± 12.8 b,c | 25 ± 5.9 a | 15 ± 10.8 a |
| 2.26 | 80 ± 3.3 c,d | 83 ± 2.7 d | 56 ± 4.9 b | 52 ± 7.4 a,b | 39 ± 11.8 a |
| 4.52 | 83 ± 2.2 c | 96 ± 7,2 e | 79 ± 7.9 a,b | 59 ± 9.8 a | 77 ± 1.0 b,c |
| 6.78 | 100 ± 0.0 d | 100 ± 0.0 d | 73 ± 12.8 b,c | 66 ± 4.9 a,b | 71 ± 3.9 a,b,c |
| 9.0 | 100 ± 0.0 d | 100 ± 0.0 d | 85 ± 7.9 a,c | 73 ± 3.9 b | 78 ± 0.0 b,c |
| 11.3 | 100 ± 0.0 a | 100 ± 0.0 a | 88 ± 2.0 c | 99 ± 0.9 a | 83 ± 1.0 b |
| Concentration | * Percentage of Inhibition of Mycelial Growth of B. cinerea (%) ± SD | ||||
|---|---|---|---|---|---|
| %v/v | O. vulgare | T. vulgaris | C. sinensis | C. limon | BC-1000® |
| 0.02 | 12 ± 1.3 a.c | 15 ± 2.1 a,c | 0 ± 0.0 d | 9 ± 9.9 a,b | 0 ± 0.0 d |
| 0.1 | 25 ± 4.5 b,c,d | 26 ± 14.5 c,d | 11 ± 7.9 a,b | 14 ± 2.0 a,b,c | 0 ± 0.0 a |
| 0.2 | 25 ± 2.5 c | 26 ± 3.7 c | 8 ± 6.0 a,d | 18 ± 3.4 a,b,c | 0 ± 0.0 d |
| 1 | 47 ± 1.3 b,c | 67 ± 12.2 c,d,e | 50 ± 7.9 b | 22 ± 3.0 a | 15 ± 10.8 a |
| 5 | 62 ± 16.3 b | 64 ± 16.6 b,c | 56 ± 9.3 a,b | 39 ± 5.9 a | 39 ± 11.8 a |
| 10 | 64 ± 10.3 a,d | 75 ± 0.0 b,c,d | 67 ± 9.7 a,b | 59 ± 1,1 a | 77 ± 1.0 b,c |
| 15 | 72 ± 3.3 b,c | 79 ± 15.3 c | 80 ± 1.1 c | 60 ± 3.0 a | 71 ± 3.9 a,b,c |
| 20 | 83 ± 8.2 a,c | 82 ± 0.0 a,c | 88 ± 5.7 a | 86 ± 0.0 a | 78 ± 0.0 b,c |
| 25 | 100 ± 0.0 a | 92 ± 5.5 c | 84 ± 3.9 b | 100 ± 0.0 a | 83 ± 1.0 b |
| Antifungal Agent | EO, %v/v × 10−2 (ppm) | HYS, %v/v |
|---|---|---|
| O. vulgare | 2.2 ± 0.07 f (19.8) | 2.5 ± 0.8 b,c,d |
| T. vulgaris | 1.8 ± 0.06 f (15.9) | 2.1 ± 0.7 a,b,c,d |
| C. sinensis | 9.4 ± 0.06 d (83.2) | 0.7 ± 0.9 a,b |
| C. limon | 22.2 ± 0.06 b (196.2) | 7.6 ± 0.9 e |
| BC-1000® (C+) | 270.8 ± 0.02 a | |
| Carvacrol | (18.6) * | |
| Thymol | (18.9) * | |
| O. compactum | (35.1) * | |
| T. glandulosus | (79.1) * |
| Compounds | a Percentage T. vulgaris | b RT (min.) T. vulgaris | a Percentage O. vulgare | b RT (min.) O. vulgare |
|---|---|---|---|---|
| α-Terpinenol | - | - | 18.35 | 8.859 |
| β-Cymene | 17.52 | 9.144 | 3.11 | 9.142 |
| γ-Terpinene | 3.30 | 10.331 | 32.48 | 10.334 |
| Terpinolene | - | - | 7.47 | 11.348 |
| β-Linalool | 3.42 | 11.741 | 5.11 | 11.742 |
| Borneol | 2.81 | 13.937 | - | - |
| Terpinen-4-ol | - | - | 19.01 | 14.315 |
| α-Terpineol | - | - | 2.89 | 14.744 |
| Isothymol methyl ether | 1.90 | 16.416 | 2.70 | 16.418 |
| p-Thymol | 56.62 | 17.919 | 5.45 | 17.879 |
| β-Caryophyllene | - | - | 3.43 | 21.527 |
| Carvacrol | 5.11 | 18.161 | - | - |
| Disease Incidence Percentage of Gray Mold Disease (%) ± SD | |||||||
|---|---|---|---|---|---|---|---|
| Plants | Treatments | Concentration (%v/v) | 1 dpi | 2 dpi | 3 dpi | 4 dpi | 5 dpi |
| Thyme | EO/HYS | 6.7 × 10−2/15 | 0 ± 0.0 a | 16.7 ± 14.3 a,c,d | 50.0 ± 25.0 c | 83.3 ± 14.3 b,c | 91.7 ± 14.3 b |
| HYS | 15 | 8.3 ± 14.3 a,b | 25 ± 25.0 a,c,d | 58.3 ± 28.6 b,c | 75 ± 25.0 c,d | 100 ± 0.0 b | |
| EO/HYS | 13.5 × 10−2/30 | 0 ± 0 a | 8.3 ±14.3 a,c | 33.3 ± 28.6 a | 58.3 ± 14.3 d | 91.7 ± 14.3 b | |
| HYS | 30 | 8.3 ± 14.3 a,b | 25 ± 25.0 a,c,d | 33.3 ± 14.3 a | 75 ± 14.3 c,d | 91.7 ± 14.3 b | |
| Oregano | EO/HYS | 6.7 × 10−2/15 | 0 ± 0 a | 33.3 ± 12.5 a,b | 87.8 ± 12.5 b | 100.0 ± 0.0 b | 100.0 ± 0.0 b |
| HYS | 15 | 16.7 ± 28.8 a,b | 66.7 ± 14.3 b | 83.3 ±14.3 b,c | 91.7 ± 14.3 b,c | 100.0 ± 0.0 b | |
| EO/HYS | 13.5 × 10−2/30 | 0 ± 0 a | 33.3 ± 28.8 a,b | 75.0 ± 25.0 b,c | 91.7 ± 14.3 b,c | 100.0 ± 0.0 b | |
| HYS | 30 | 8.3 ± 14.3 a,b | 33.3 ± 1.3 a,b | 66.7 ± 25.0 b,c | 91.7 ± 14.3 b,c | 100.0 ± 0.0 b | |
| C (+) | BC-1000® | 6.7 × 10−2 | 16.7 ± 14.3 b | 58.3 ± 14.3 b,d | 83.3 ± 14.3 b,c | 100.0 ± 0.0 b | 100.0 ± 0.0 b |
| 13.5 × 10−2 | 25.0 ± 0.0 a,b | 50.0 ± 0.0 b,d | 75.0 ± 25.0 b,c | 100.0 ± 0.0 b | 100.0 ± 0.0 b | ||
| Control | Inoculum | - | 8.3 ± 14.4 a,b | 41.7 ± 52.0 b | 83.3 ± 28.8 b,c | 100 ± 0.0 b | 100 ± 0.0 b |
| Water | - | 0 ± 0.0 a | 0 ± 0.0 a | 0 ± 0.0 a | 0 ± 0.0 a | 0 ± 0.0 a | |
Publisher’s Note: MDPI stays neutral with regard to jurisdictional claims in published maps and institutional affiliations. |
© 2021 by the authors. Licensee MDPI, Basel, Switzerland. This article is an open access article distributed under the terms and conditions of the Creative Commons Attribution (CC BY) license (https://creativecommons.org/licenses/by/4.0/).
Share and Cite
Brito, C.; Hansen, H.; Espinoza, L.; Faúndez, M.; Olea, A.F.; Pino, S.; Díaz, K. Assessing the Control of Postharvest Gray Mold Disease on Tomato Fruit Using Mixtures of Essential Oils and Their Respective Hydrolates. Plants 2021, 10, 1719. https://doi.org/10.3390/plants10081719
Brito C, Hansen H, Espinoza L, Faúndez M, Olea AF, Pino S, Díaz K. Assessing the Control of Postharvest Gray Mold Disease on Tomato Fruit Using Mixtures of Essential Oils and Their Respective Hydrolates. Plants. 2021; 10(8):1719. https://doi.org/10.3390/plants10081719
Chicago/Turabian StyleBrito, Conny, Henrik Hansen, Luis Espinoza, Martín Faúndez, Andrés F. Olea, Sebastián Pino, and Katy Díaz. 2021. "Assessing the Control of Postharvest Gray Mold Disease on Tomato Fruit Using Mixtures of Essential Oils and Their Respective Hydrolates" Plants 10, no. 8: 1719. https://doi.org/10.3390/plants10081719
APA StyleBrito, C., Hansen, H., Espinoza, L., Faúndez, M., Olea, A. F., Pino, S., & Díaz, K. (2021). Assessing the Control of Postharvest Gray Mold Disease on Tomato Fruit Using Mixtures of Essential Oils and Their Respective Hydrolates. Plants, 10(8), 1719. https://doi.org/10.3390/plants10081719

